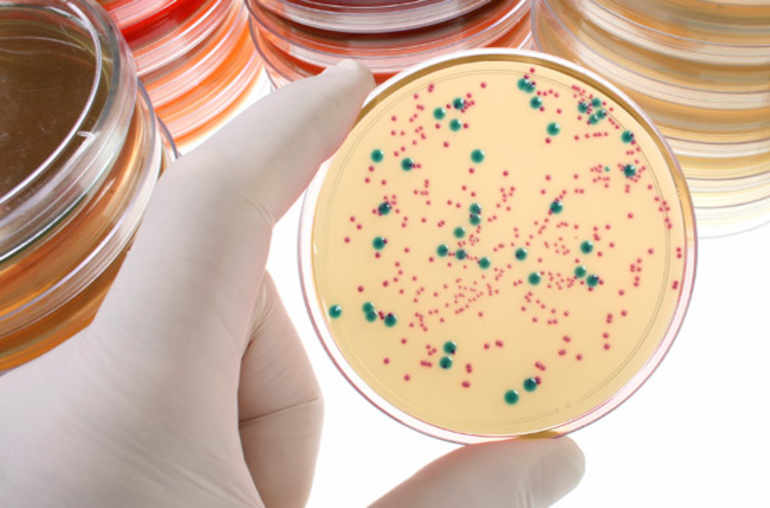

Nos bactéries intestinales pourraient augmenter l’efficacité de certains traitements anticancéreux
«Microbiote intestinal»? Il est de plus en plus souvent présenté comme un «organe oublié». Il est constitué de la flore intestinale, soit un nombre proprement inimaginable de microorganismes: dix mille milliards (dix fois plus que le nombre de cellules qui composent le corps d’un être humain). Les progrès accomplis dans le domaine de la génétique et de la biologie moléculaire font que cette gigantesque flore est depuis quelques années disséquée, répertoriée, mieux comprise. Cette terra incognita s’éclaire. On découvre que ce microbiote est composé d’environ un millier d’espèces bactériennes différentes qui peuvent au final être classées en quatre groupes principaux: Bacteroides, Firmicutes, Proteobacteria, et Actinobacteria.
On comprend mieux, aussi, les dynamiques individuelles qui sont ci en jeu. Le microbiote est acquis par l’enfant au moment de sa naissance, avant de se compléter –au cours de ses premières années– sous diverses influences, la principale étant la nature des apports alimentaires. Ce qui conduit à faire du microbiote de chacun, un microbiote véritablement unique. On prend aussi de mieux en mieux la mesure des rôles joués par cette flore intestinale dans différents aspects des métabolismes de notre organisme: dégradation et digestion des fibres alimentaires, synthèse de certaines vitamines, actions majeures sur la fonction intestinale.
Le «soi» et le «non-soi»
Mais il y a plus encore. Les microorganismes constitutifs du microbiote contribuent également au développement et au bon fonctionnement de notre système immunitaire – la reconnaissance du «soi» contre les agressions du «non-soi». De ce point de vue, le microbiote intestinal pourrait constituer un levier permettant d’augmenter l’efficacité de certains traitements anticancéreux, des traitements nouveaux connus sous le nom d’immunothérapies. Il s’agit ici schématiquement d’agir sur le système immunitaire pour lutter contre un processus cancéreux. Là encore, les progrès de la biologie moléculaire suscitent, depuis quelques années, de nombreux espoirs.
C’est dans ce contexte que viennent d’être publiées, dans la revue américaine Science, deux études qui se situent au croisement de la compréhension du microbiote et de l’action des immunothérapies. «Pourquoi certains patients répondent-ils bien aux immunothérapies et d'autres non? La réponse n'est pas claire, mais deux nouvelles études offrent des preuves du rôle du microbiote intestinal», résume Science.
Une dizaine de cancers
De fait, tout n’est pas simple dans le choix et le maniement des immunothérapies chez des personnes souffrant de cancer. Aujourd’hui trois spécialités pharmaceutiques de ce type sont commercialisées dans l’Union européenne: l'ipilimumab, le pembrolizumab et le nivolumab. Elles sont indiquées dans différents types de cancers (mélanomes, cancers du poumon) et en cours d’évaluation dans une dizaine d'autres types de cancers.
Parmi les différents obstacles pouvant apparaître dans le maniement de ces molécules, les équipes médicales doivent compter avec un acteur bien particulier, longtemps inconnu ou très largement sous-estimé. Il s’agit, à l’interface des cellules cancéreuses et des mécanismes immunitaires, des bactéries intestinales. C’est ce que montre la première des deux études qui vient d’être publiée dans Science1. Elle a été effectuée sous la direction de la Pre Laurence Zitvogel, directrice d'unité Inserm à Gustave-Roussy (Villejuif). Ce travail multidisciplinaire a été mené sur des souris atteintes de tumeurs chez lesquelles on a évalué l’efficacité d’une immunothérapie en jouant sur la variable «flore intestinale». Les chercheurs ont analysé les selles de ces rongeurs pour identifier les bactéries présentes. «L'immunothérapie perd son efficacité quand la flore des rongeurs est dépourvue de deux bactéries du groupe des Bacteroides immunogènes, dont Bacteroides fragilis»,indique la Pr Zitvogel. Apporter cette bactérie aux animaux permet de retrouver l’efficacité de la thérapie.
Test prédictif
Ces observations ont pu être confortées par des analyses effectuées sur des flores intestinales de personnes souffrant de mélanomes et traitées par ipilimumab ainsi que par des expériences de transplantations fécales sur des souris de laboratoire. «Ces résultats doivent être validés chez l'homme», a toutefois expliqué au Monde Caroline Robert (Institut Gustave-Roussy), cosignataire de l'étude. Les chercheurs français élaborent actuellement différentes expériences pour confirmer leurs observations. «Nous espérons mettre au point un test qui prédise la réponse à ce traitement par des analyses fécales simples», poursuivait la Pr Laurence Zitvogel. Une autre perspective concrète est de parvenir à proposer des traitements qui permettraient de moduler la composition du microbiote des malades de manière à potentialiser les effets du traitement.
La deuxième publication de Science2 est signée par une équipe de chercheurs dirigée par le Pr Thomas Gajewski (Université de Chicago). Les auteurs ont comparé les résultats d'une autre immunothérapie chez deux souches de souris dont les microbiotes sont très différents. Résultats: le traitement apparaît nettement plus efficace chez les souris dont la flore est particulièrement riche en Bifidobacterium, une bactérie lactique. Et, là encore, en organisant des «transferts de selles» entre souris des deux souches, les chercheurs parviennent à améliorer le contrôle des tumeurs. On sait par ailleurs que Bifidobacterium est présent dans de nombreuses préparations laitières et le lancement d’essais cliniques pourrait, de ce fait, ne pas tarder.
Des études prometteuses qui éclairent toujours plus le rôle de notre microbiote.
_________
1. Un résumé (en anglais) de cette étude est disponible ici: «Anticancer immunotherapy by CTLA-4 blockade relies on the gut microbiota»
2. Un résumé (en anglais) de cette étude est disponible ici: «Commensal Bifidobacterium promotes antitumor immunity and facilitates anti–PD-L1 efficacy»

Dans le secret de nos intestins

Les mystères (infinis) du microbiote




